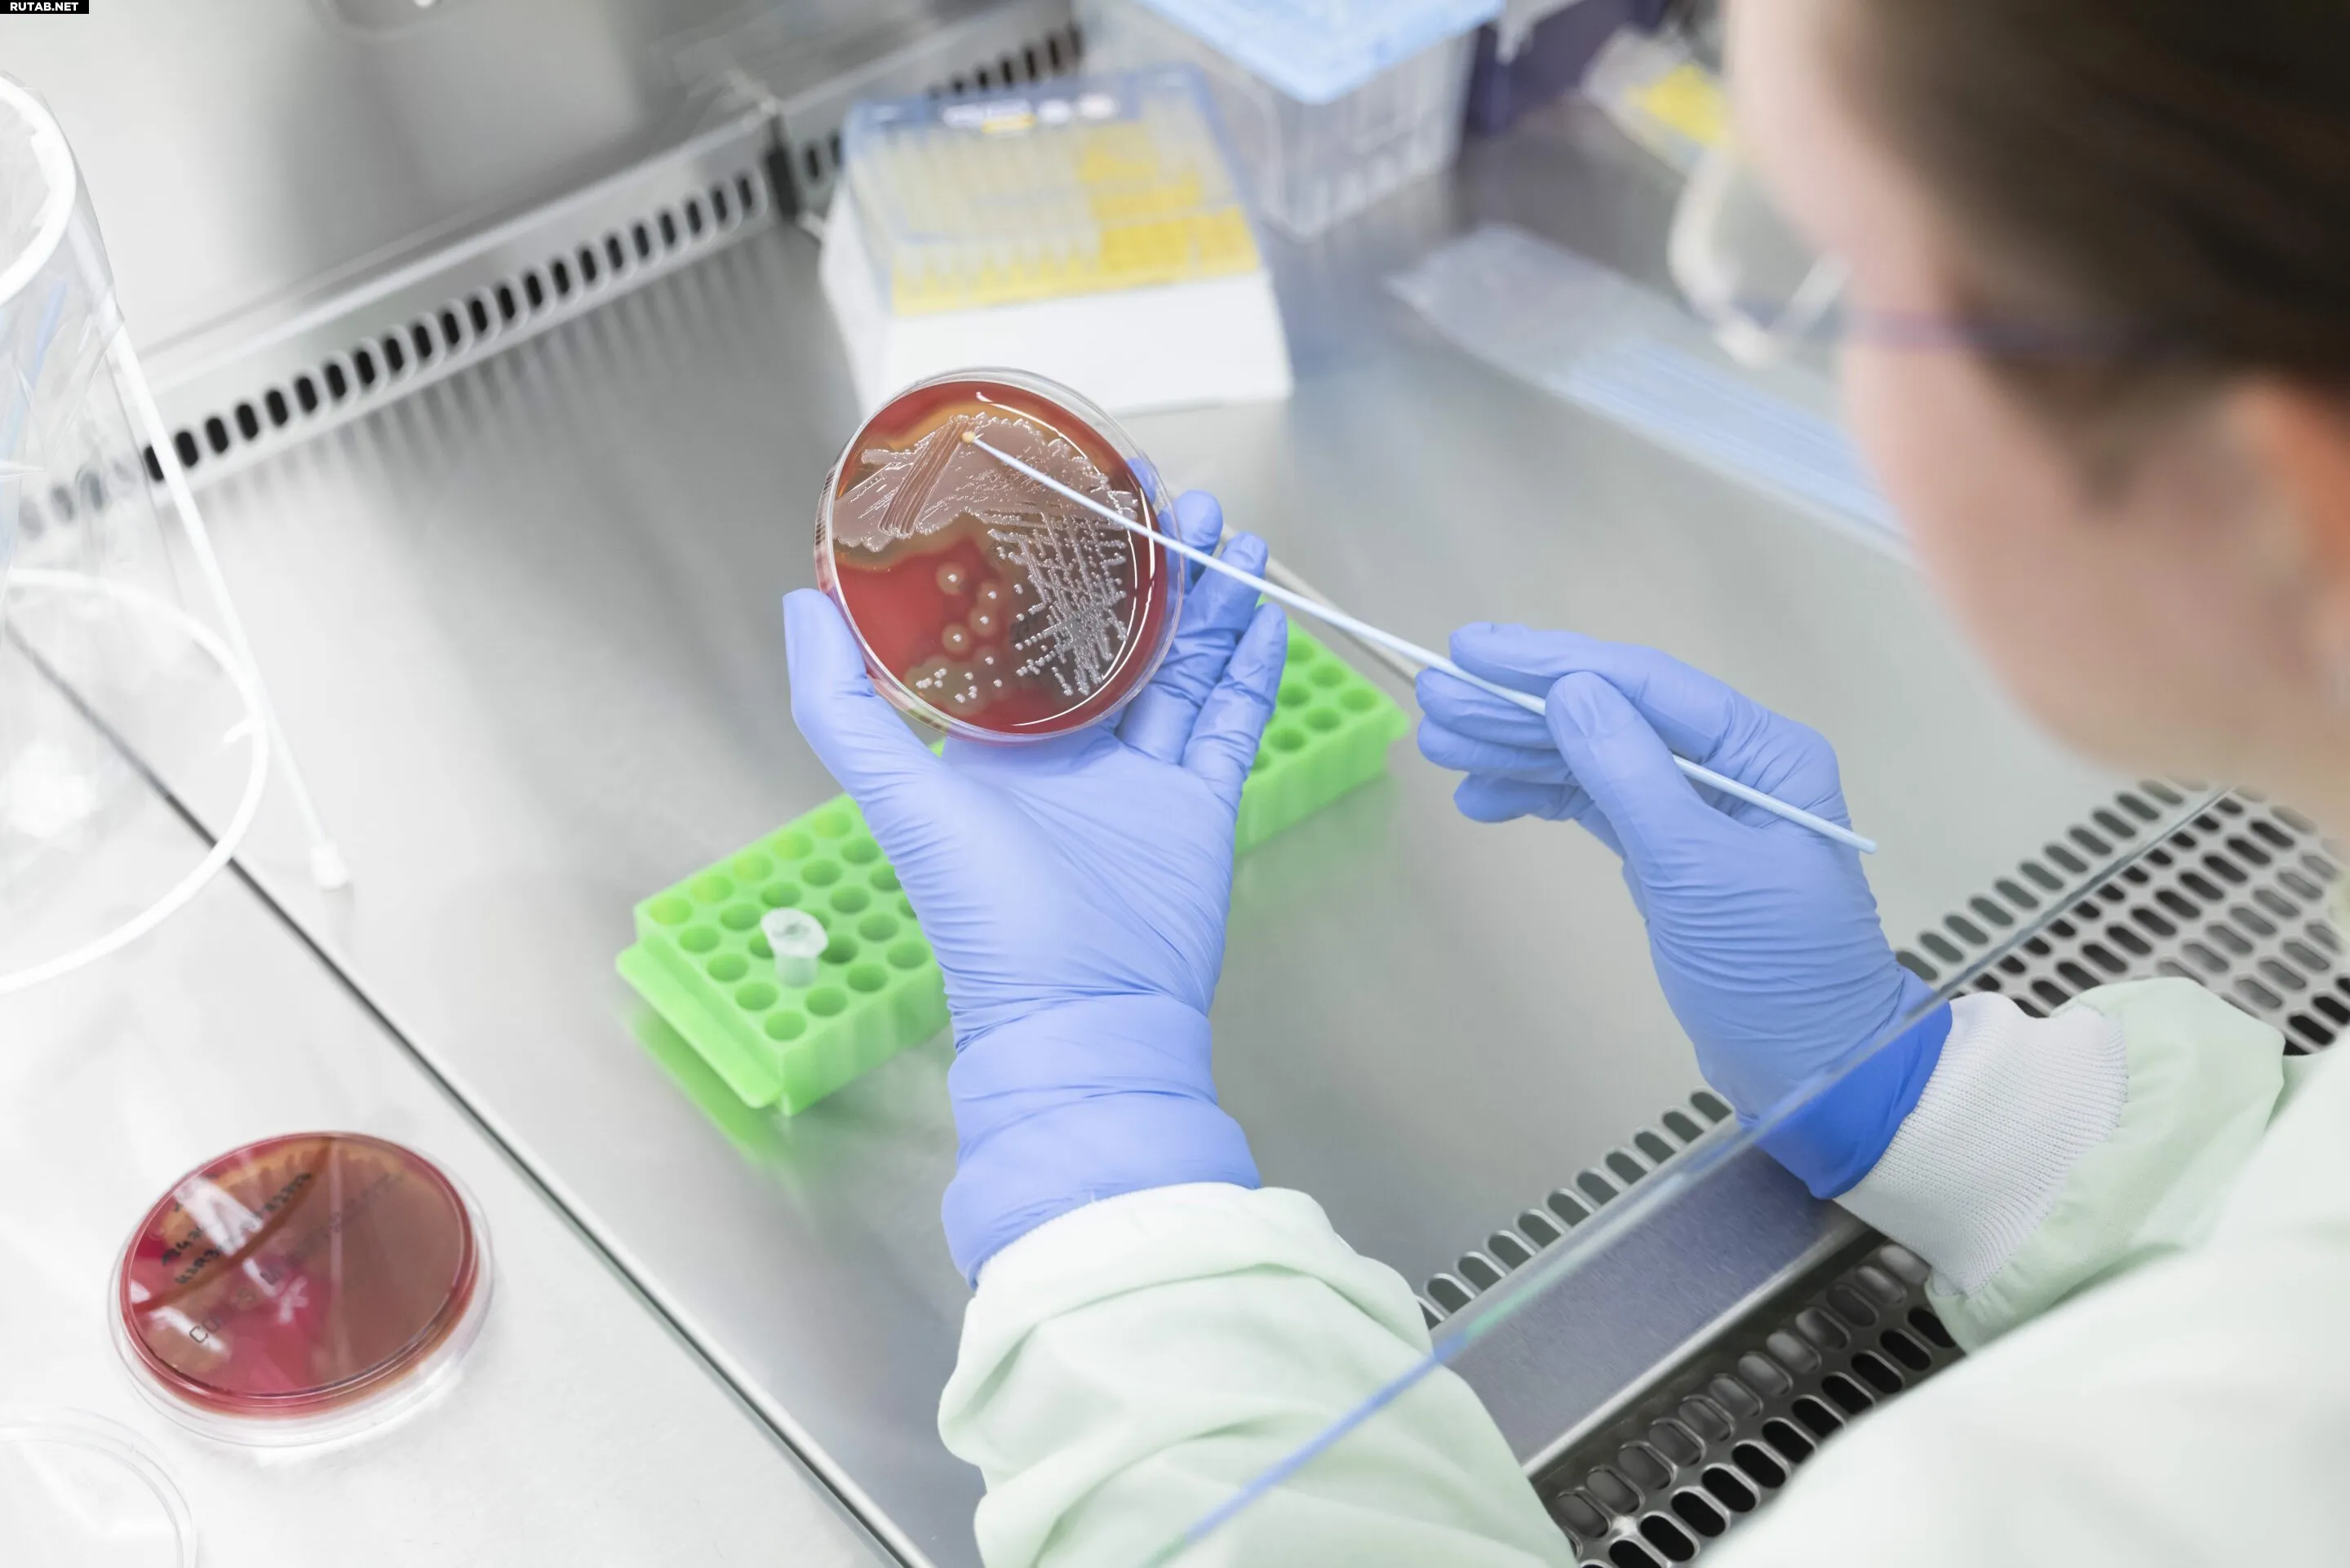

Новая диагностическая платформа поможет выявить пробелы в вакцинации и устойчивость к антибиотикам
Ученый Института фотонных технологий Лейбница Эльке Мюллер берет образец бактерий с агаровой пластины. Автор: Свен Дёринг
Ученые из Института фотонных технологий Лейбница разработали новую диагностическую платформу на основе микрочипов, которая может помочь выявить пробелы в вакцинации и быстро обнаружить устойчивые к антибиотикам бактерии.
Инновация, созданная в исследовательском кампусе InfectoGnostics в Йене, направлена на ускорение двух важнейших областей здравоохранения: мониторинга иммунитета после вакцинации и более эффективного выявления устойчивых к лекарствам патогенов. В исследовании, опубликованном в Frontiers in Microbiology, ученые показали, что их новый чип идентифицирует оптимальные пары антител для диагностики резистентности всего за несколько дней вместо недель.
«Наша платформа сокращает поиск подходящих антител с нескольких недель до всего нескольких дней», — заявил первый автор исследования Саша Д. Браун. «Это означает, что новые диагностические тесты можно разрабатывать гораздо быстрее — ключевое преимущество при работе с устойчивыми к антибиотикам инфекциями, которые становится все сложнее лечить».
Борьба с устойчивостью к антибиотикам последнего резерва
Исследование сосредоточено на антителах, нацеленных на бактериальные ферменты, ответственные за инактивацию основных классов антибиотиков. Среди них карбапенемазы, которые делают неэффективными почти все бета-лактамные антибиотики, и MCR-1, который позволяет грамотрицательным бактериям, таким как кишечная палочка, сопротивляться колистину — одному из немногих оставшихся антибиотиков, доступных когда другие не работают.
В отличие от обычных ELISA-тестов, микрочип йенской команды тестирует все антитела одновременно в режимах «захвата» и «обнаружения». Этот параллельный подход экономит время и исключает многочисленные ручные этапы. Из 49 протестированных антител около 20% дали сильные воспроизводимые сигналы — пригодные для использования в экспресс-тестах, таких как иммунохроматографические анализы.
От кори до COVID-19: визуализация иммунной защиты
Корни платформы восходят к 2022 году, когда исследователи продемонстрировали, что тот же микрочип может обнаруживать антитела против вакцинных антигенов для таких заболеваний, как корь, столбняк и COVID-19. Визуализируя гуморальный иммунный ответ — образование антител в крови — чип может показать, есть ли у человека достаточная защита после вакцинации.
Достаточно всего одной капли крови. Антигены патогенов, закрепленные на микрочипе, действуют как молекулярные «ловушки». Когда антитела связываются с этими мишенями, тест показывает, существует ли защитный иммунитет.
Потребность в таких инструментах растет: по данным ВОЗ и ЮНИСЕФ, в 2024 году в Европейском регионе ВОЗ было зарегистрировано более 127 000 случаев кори — вдвое больше, чем в предыдущем году. Во многих странах уровень вакцинации снизился после пандемии COVID-19.
«Мы хотели создать гибкую тестовую платформу, которая может быстро реагировать на новые угрозы для здоровья — будь то новый патоген, пробел в вакцинации или устойчивая инфекция», — сказал профессор Ральф Эрихт, руководитель проекта в Институте Лейбница и Йенском университете.
Модульный инструмент для исследований, диагностики и промышленности
Оба исследования являются частью проекта RESISTOVAC. Цель — разработать открытую модульную мультипараметрическую платформу, которая может быстро определять как статус вакцинации, так и профили бактериальной резистентности.
Благодаря модульной архитектуре платформу можно в любое время расширять новыми антителами или целевыми структурами — важное преимущество, поскольку инфекционные и устойчивые заболевания продолжают расти во всем мире.

0 комментариев